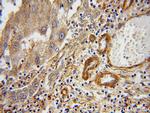
ERI1 Antibody in Immunohistochemistry (Paraffin) (IHC (P))
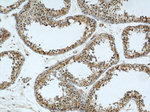
ERI1 Antibody in Immunohistochemistry (Paraffin) (IHC (P))

Search
Proteintech
ERI1 Polyclonal Antibody
{{$productOrderCtrl.translations['antibody.pdp.commerceCard.promotion.promotions']}}
{{$productOrderCtrl.translations['antibody.pdp.commerceCard.promotion.viewpromo']}}
{{$productOrderCtrl.translations['antibody.pdp.commerceCard.promotion.promocode']}}: {{promo.promoCode}} {{promo.promoTitle}} {{promo.promoDescription}}. {{$productOrderCtrl.translations['antibody.pdp.commerceCard.promotion.learnmore']}}
产品信息
14592-1-AP
种属反应
宿主/亚型
分类
类型
抗原
偶联物
形式
浓度
规格
纯化类型
保存液
内含物
保存条件
运输条件
产品详细信息
Immunogen sequence: MEDPQSKEP AGEAVALALL ESPRPEGGEE PPRPSPEETQ QCKFDGQETK GSKFITSSAS DFSDPVYKEI AITNGCINRM SKEELRAKLS EFKLETRGVK DVLKKRLKNY YKKQKLMLKE SNFADSYYDY ICIIDFEATC EEGNPPEFVH EIIEFPVVLL NTHTLEIEDT FQQYVRPEIN TQLSDFCISL TGITQDQVDR ADTFPQVLKK VIDWMKLKEL GTKYKYSLLT DGSWDMSKFL NIQCQLSRLK YPPFAKKWIN IRKSYGNFYK VPRSQTKLTI MLEKLGMDYD GRPHCGLDDS KNIARIAVRM LQDGCELRIN EKMHAGQLMS VSSSLPIEGT PPPQMPHFRK (1-349 aa encoded by BC035279)
靶标信息
RNA exonuclease that binds to the 3'-end of histone mRNAs and degrades them, suggesting that it plays an essential role in histone mRNA decay after replication. A 2' and 3'-hydroxyl groups at the last nucleotide of the histone 3'-end is required for efficient degradation of RNA substrates. Also able to degrade the 3'-overhangs of short interfering RNAs (siRNAs) in vitro, suggesting a possible role as regulator of RNA interference (RNAi). Requires for binding the 5'-ACCCA-3' sequence present in stem-loop structure. Able to bind other mRNAs. Required for 5.8S rRNA 3'-end processing. Also binds to 5.8s ribosomal RNA. Binds with high affinity to the stem-loop structure of replication-dependent histone pre-mRNAs.
仅用于科研。不用于诊断过程。未经明确授权不得转售。
篇参考文献 (0)
生物信息学
蛋白别名: 3 ' exoribonuclease; 3' exoribonuclease; 3'-5' exonuclease ERI1; 3'-5' exoribonuclease 1; 3'hExo; enhanced RNAi protein 1; enhanced RNAi three prime mRNA exonuclease homolog 1; Eri-1 homolog; HEXO; histone mRNA 3' end-specific exonuclease; Histone mRNA 3'-end-specific exoribonuclease; Histone mRNA 3'-exonuclease 1; protei; Protein 3'hExo; three prime histone mRNA exonuclease 1; three prime mRNA exonuclease 1; unnamed protein product
基因别名: 3'EXO; 3'HEXO; 3110010F15Rik; eri-1; ERI1; HEXO; HXAL; RGD1308378; SEMDGC; SEMDGS; THEX1
UniProt ID: (Human) Q8IV48, (Rat) Q5FVR4, (Mouse) Q7TMF2
Entrez Gene ID: (Human) 90459, (Rat) 361159, (Mouse) 67276